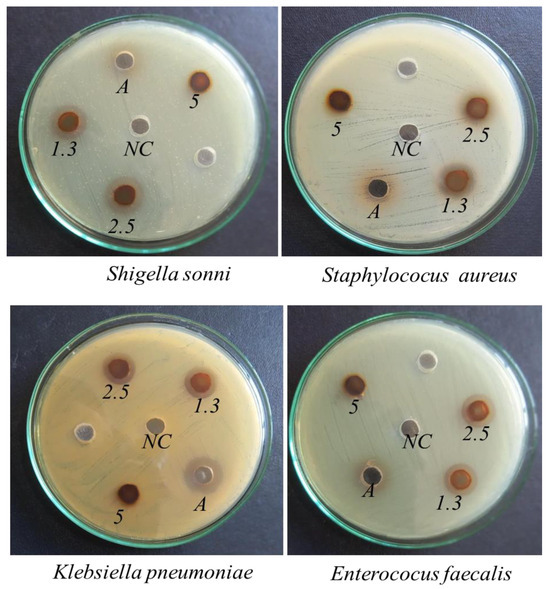

Abstract
Plant-based preparation of nanomaterials has become a recent global research focus due to its cost-effectiveness, sustainability, and environmentally friendly approach. This study aims to synthesize silver nanoparticles (HAgNPs) using red lentil husk aqueous extract (LHE) and to assess its antibacterial activity. Synthesized HAgNPs were analyzed by ultraviolet-visible spectroscopy (UV-vis.), Fourier transform infrared spectroscopy (FTIR), X-ray diffraction spectroscopy (XRD), field emission scanning electron microscopy (FESEM), and energy dispersive X-ray (EDX) analysis. The antibacterial efficacy of synthesized HAgNPs was investigated against Staphylococcus aureus (ATCC No: 25923), Enterococcus faecalis (ATCC No: 29212), Klebsiella pneumoniae (ATCC No: 700603), and Shigella sonnei (ATCC No: 25931) at varying concentrations via the agar well diffusion scheme. The UV-vis absorption maximum observed around 420 nm directed the creation of HAgNPs. The shifting of peak positions in the FTIR spectrum of the synthesized HAgNPs compared to the FTIR spectrum peak positions of LHE indicated the involvement of biomolecules present in LHE in reducing silver ions to metallic silver. XRD examination of the prepared sample suggested face-centred cubic crystals of the HAgNPs. The average particle dimension of prepared HAgNPs was 8.9 nm by the Debye–Scherer equation. An FESEM examination of the synthesized HAgNPs revealed spherical morphology, while the EDX study showed that silver (Ag0) was the predominant component, comprising 62.3% by weight. The synthesized HAgNPs displayed a higher DPPH radical scavenging capacity (IC50 = 38.87 ± 3.52 µg/mL) than that of LHE (IC50 = 65.27 ± 1.17 µg/mL). The prepared HAgNPs exhibited significant antibacterial efficacy against some human pathogen bacteria at lower concentrations. Hence, the present study highlights an environmentally benevolent and economical synthetic approach to the preparation of HAgNPs and its potential utility for the production of biomedical products.
1. Introduction
Currently, many global researchers are concentrating on various types of metal nanoparticles (NPs) because of their unique properties. Some unique properties of metal NPs are their distinct physicochemical characteristics that promote antibacterial, anticancer activity, electronic, catalytic, and optical properties, etc. [1]. These distinct and novel properties of NPs differ significantly from their bulk counterpart’s properties because of their reduced size and larger surface area [2].
These days NPs are created via different physical, chemical, biological methods, etc. Physical methods (UV irradiation, pyrolysis, laser ablation, physical vapour deposition etc.) require high-energy sources and normally result in low yields, while the chemical methods requires different toxic chemicals (sodium borohydride, hydrazine hydrate, ethanol, N, N-dimethylformamide, ethylene glycol, sodium formaldehyde, and sulfoxylate, etc.) which are difficult to purify, costly, and may contain biological risk [3]. While biological methods, also known as green methods, are suggested to be simple, appropriate, cheap, and environment-benign approaches that alleviate the application of noxious chemicals [4]. With these methods, especially the plant-based fabrication of nanoparticles, usually extracts of different plant parts are used. Different biomolecules (quinones, flavonoids, saponins, terpenoids, etc.) existing in the plant extracts are recommended as bio-reductants for the metal ion to produce metal nanoparticles. Furthermore, these biomolecules existing in the plant extract can function as capping and stabilizing agents [5,6]. To date, many plant parts (barks, leaves, roots, flowers, seeds, etc.) extracts have been applied in nanotechnological applications [7]. Moreover, the plant-mediated fabrication of NPs is more popular in comparison to other biological synthetic routes for the preparation of NPs because of the ease of preparation, its less hazardous nature, and, notably, because the procedure can be appropriately ascended for the large-scale synthesis of different nanoparticles [8,9]. Among different metal NPs, AgNPs possess many diverse physicochemical, biological, optoelectrical, and antimicrobial characteristics, making them an innovative category of nanomaterial [10].
Furthermore, these days, the antimicrobial resistance (AMR) of microorganisms is increasing; as a result, medicines can become infective during the treatment of diseases, which potentially may lead to common infections becoming untreatable, requiring routine surgeries. Microorganisms that develop drug resistance are called superbugs, and this phenomenon is also referred to as a silent pandemic [11]. AMR poses a significant global health threat, as it can lead to prolonged illness, increased mortality, and higher healthcare costs. AMR was estimated to cause about 4.95 million deaths worldwide by 2019, posing a significant challenge to the global healthcare system [12].
Thus, combating antimicrobial resistance is crucial for preserving public health and ensuring the efficacy of existing and future antimicrobial therapies. To address the antimicrobial resistance of drugs, strategies should include developing new antimicrobial agents for agriculture, health, livestock, etc. Hence, from this perspective, many researchers are devoted to finding nanomaterials that could have efficient antibacterial properties. Studies have revealed that silver nanoparticles own a wide spectrum of antimicrobial properties. A contemporary study by Khanal et al. used aqueous root extracts of Rubus ellipticus for AgNPs fabrication and reported significant antimicrobial properties [13]. Similarly, Sharifi-Rad et al. prepared AgNPs using Lallemantia royleana leaf extracts and showed the medical as well as catalytic activity of the synthesized AgNPs [14]. Another study by Vinay et al. prepared cubic-phase AgNPs from Rauvolfia tetraphylla leaf extract with particle sizes of around 40 nm and demonstrated good anti-microbial activity against different bacteria [7]. (Likewise) the green synthesis of AgNPs by Gmelina arborea extract exhibited antibacterial effectiveness against several pathogenic bacteria by the disc diffusion method [15]. Similarly, AgNPs were prepared by an aqueous leaf extract of Premna integrifolia (L.) at a neutral pH. This showed effective antibacterial properties against different bacteria [16].
It is well known that green and sustainable chemistry demands the utilization of waste material for fruitful proposes. However, the biosynthesis of AgNPs using waste red lentil (Lens culinaris) husk aqueous extract and their bioactivity studies are not well documented. Hence, this study aims to use waste red lentil husk aqueous extract (LHE) as a silver ion-reductant, capping, and stabilizing mediator for the synthesis of HAgNPs for the first time. Characterization of the prepared HAgNPs was performed via scientific tools, namely UV-vis spectroscopy, XRD, FESEM, EDX, etc. Furthermore, the antibacterial test against some pathogen bacteria and in vitro-antioxidant test of synthesized HAgNPs were also accessed.
2. Materials and Methods
2.1. Materials
The AR/LR grade chemicals were used as purchased. The silver nitrate, ethanol, and dimethyl sulphoxide were from Thermo Fisher Scientific India Pvt. Ltd., Mumbai, India; the Muller Hinton Agar (MHA), and Muller Hinton Broth (MHB) were from Himedia Pvt., Ltd., Mumbai, India. The DPPH was from Tokyo Chemical Industries Co., Ltd., Tokyo, Japan.
2.2. Preparation of Red Lentil Husk Aqueous Extract (LHE)
Red lentil husk was received from a local salesperson, and dirt on the husk was removed using distilled water. The cleaned husk was then dried and ground to make powder via a mixture grinder. LHE was made by mixing 5 g dried husk powder in 50 mL distilled water. The mixture was boiled for about 5 min. The solution was then cooled and, finally, the filtrate was collected by filtering the mixture through Whatman filter paper No. 41. It was placed in a closed container in the fridge at 4 °C.
2.3. Preparation of Red Lentil Husk Extract-Mediated Silver Nanoparticles (HAgNPs)
HAgNPs were prepared by taking AgNO3 solution and LHE as reducing and capping agents, as described elsewhere. In short, about 200 mL of 1mM silver nitrate was taken in a 500 mL container. Then, twenty millilitres of husk aqueous extract were placed into a burette and added drop by drop in a stirring condition using a magnetic stirrer at the lab temperature (20 ± 2) °C. After the complete addition of the plant extract, the dark-reddish-brown-coloured solution was obtained within half an hour, indicating the formation of HAgNPs. The colloidal solution was then placed in a dark area for twenty-four hrs. After twenty-four hrs., it was centrifugated at 8000 rpm for about 30 min and cleaned repeatedly with distilled water. Washed HAgNPs were then collected in a 2 mL vile and again centrifuged at 14,000 rpm for about twenty minutes (centrifuge machine, Thermo Scientific, Sorvall ST 8R centrifuge). Finally, pellets of HAgNPs were washed with ethanol and were kept in a desiccator for drying. The dehydrated HAgNPs were deposited in a closed vessel in the fridge for investigation.
2.4. Characterization
Characterization of the as-synthesized HAgNPs was achieved by taking UV-vis absorption spectra using a UV-vis spectrophotometer (Specord 200 plus, Analytikjena, Jena, Germany) in the range of 300 to 700 nm. Vibration of different functional groups present in both aqueous filtrate and synthesized HAgNPs was recorded using FT-IR spectroscopy (Shimadzu IRTracer-100, Shimadzu Corporation, Kyoto, Japan). The surface morphology of the synthesized HAgNPs was found using field emission scanning electron microscopy (FE-SEM, Hitachi, S-7400, Hitachi High-Tech Corporation, Tokyo, Japan), and the elemental composition of synthesized HAgNPs was detected using energy dispersive X-ray (EDX) analysis. The phase purity was determined from the XRD spectrum using monochromatic Cu Kα radiation (D2 Phaser Diffractometer, Bruker, Germany). The average crystallite size was calculated using the Debye–Scherrer equation (1).
“where D is the average crystallite size, K (0.9) is the broadening constant, λ is the wavelength of Cu Kα radiation (0.15406 nm), β the full-width at half maximum (FWHM) in radians, θ is the diffraction angle in degrees” [17].
2.5. Estimation of Total Phenolic Content (TPC) and Total Flavonoid Content (TFC)
The Folin–Ciocalteu method was applied to quantify the phenolic present in the prepared LHE, taking gallic acid as a standard [13,18]. A set of aqueous solutions were made by serial dilution from a stock solution. Microplate bores were filled with twenty microliter gallic acid solutions of different concentrations and lentil extract (5 mg/mL) separately. Each of the trial solutions was mixed with 100 µL of Folin–Ciocalteu reagent (diluted into 1:10 by distilled water), and 80 μL of 1N Na2CO3 solution prepared in triplicate. All the contents except the test sample were used as a blank. The microplate filled with the test solutions was covered with its lid and incubated for about thirty minutes at laboratory room temperature. The absorbance was recorded at a wavelength of 765 nm using a microplate reader (BioTek, Synergy, LX multimode reader, LA Abcoude, The Netherlands). A calibration curve was made, and the TPC in the LHE was determined and represented as mg of gallic acid equivalent per gram (GAE/g).
The TFC in LHE was estimated by using an aluminum chloride colorimetric method, taking quercetin as a standard [19,20]. Briefly, quercetin solutions were prepared by the serial dilution method. Aliquots of 130 mL of each of the quercetin solutions, along with 5 μL of AlCl3, 5 μL of CH3COONa, and 60 μL of ethanol, were introduced into the wells of a 96-well microplate in triplicate. In the other wells of the microplate, 20 μL of LHE (5 mg/mL), 110 μL of DW, 5 μL of AlCl3 and 5 μL of CH3COONa, and 60 μL ethanol were mixed to obtain a final volume of 200 μL. All of the test samples were prepared in triplicate. The sample-loaded microplate was covered with its lid and incubated in the dark at room temperature for 30 min. After incubation, the absorbance was taken at 415 nm against blank using a microplate reader. A standard curve for quercetin was drawn, and TFC was calculated and expressed as mg of quercetin equivalent per gram (QE/g).
2.6. Antioxidant Activity
The LHE antioxidant capacity and the prepared HAgNPs were evaluated by a 2, 2-diphenyl-1-picrylhydrazyl (DPPH) free radical scavenging method, taking ascorbic acid as a standard with slight modification [21,22]. The test solutions in 50% DMSO at the concentrations of 500, 250, 125, 62.5, 31.25, 15.62, and 7.8 μg/mL were prepared by serial dilution. Each test solution and standard were dispensed into the microplate bores at 100 µL, followed by the addition of 100 µL of (0.01 mM) DPPH solution in triplicate. Then, the microplate was incubated in the dark for thirty minutes and the optical density was measured at 517 nm. The obtained data were analyzed via Gen5 Microplate data collection (BioTek, Synergy, LX multimode reader) and analysis software and Microsoft Excel 2016. The DPPH free radical scavenging capacity of LHE, HAgNPs, and the ascorbic acid was calculated by applying the following relation seen below:
The half-maximal concentration that inhibits fifty per cent of the radical (IC50) values was calculated by using the linear regression analysis.
2.7. Preparation of Bacterial Inoculum
The standard ATCC organisms were incubated overnight in a nutrient broth at 37 °C, and broth turbidity was then matched with a 0.5 McFarland turbidity standard. Fresh agar plate cultures of Gram-positive Staphylococcus aureus (ATCC No. 25923) and Enterococcus faecalis (ATCC No. 29212) and Gram-negative Klebsiella pneumoniae (ATCC No. 700603) and Shigella sonnei (ATCC No. 25931) were assayed. The higher turbid growth of the organism was diluted by adding nutrient broth to match with the 0.5 McFarland turbidity standard available in the Microbiology laboratory.
2.8. Preparation of Lawn Culture Plate
A sterile cotton swab was dipped in the test tube containing the 0.5 McFarland turbidity standard of the ATCC cultures, and the excess of the culture fluid from the swab was drained. The swab was then rotated uniformly onto a dry sterile MHA plate.
2.9. Antimicrobial Activity Test
Comparative assessment of the antibacterial capacity of the synthesized HAgNPs was performed by well diffusion assay in Muller Hinton agar with slight modification [23,24]. Six wells of volume 100 microliter were made in a dry agar plate using a sterile cork-borer. A negative control (30 microliters of distilled water) was placed in the centre of the well. Thirty microliters of each HAgNP sample (1.3, 2.5, and 5 mg/mL) were kept in other wells by a micropipette, and, in one of the wells, 30 microliters of crude aqueous extract (A) were added. After diffusion of the nanoparticles, the plates were incubated at 37 °C for 24 h to see their antibacterial efficacy.
2.10. Statistical Analysis
The experiments were conducted in triplicate, with results being expressed as mean ± standard deviation. “Origin 2018” software (OriginLab Corporation, Northampton, MA, USA) was used for the graphical representation of the obtained FTIR, and XRD data. Image J software (Image J, NIH, Bethesda, MD, USA) was applied for particle size determination.
3. Results and Discussion
3.1. UV-Vis Spectroscopic Analysis
These days, numerous plant-mediated synthesizes of nanoparticles are becoming popular [13]. Upon adding aqueous plant extract to a silver ion precursor solution, the metal ions are reduced to free metal nanoparticles. In this study, when silver nitrate solution (1 mM, 200 mL) was treated with an aqueous extract (20 mL), there was a visible colour change from a light reddish brown reaction mixture solution to a dark reddish brown solution, signifying HAgNP formation. UV-visible spectroscopy is an advisable technique for indicating nanoparticle manufacturing. Thus, AgNP synthesis was further confirmed with the help of the observed UV-visible spectrum of the colloidal solution at different time intervals, as displayed in Figure 1. As we can see, there is an increase in absorption peak intensity upon increasing the reaction time, indicating that there was more AgNPs production with time. In AgNPs, the valence band and the conduction band are very close and can move freely. These free electrons can collectively oscillate to give rise to the surface plasmon resonance absorption band [25]. The molecular absorption maximum observed at 420 nm closely resembles the results of Khanal et al. (2022), confirming the formation of silver nanoparticles [13]. Although the present investigation confirmed the successful production of AgNPs with the help of plant extract, a control experiment without the extract to evaluate spontaneous reduction in Ag+ ions in an aqueous solution was not conducted. Future work should include such a comparison to better understand the specific role of extraction nanoparticle synthesis. The band gap energy of prepared HAgNPs was assessed by a UV-vis spectrum and drawing a Tauc plot (Figure 1b) and found to be 2.56 eV. The obtained result is slightly greater than the previous result [26], whereas, in another study, the band gap was evaluated as 2.79 eV [27], which is slightly greater than this study. The obtained band gap energy suggests that prepared HAgNPs may have applications for advanced optoelectronic devices and sensors [26].

Figure 1.
(a) UV-visible absorption spectra as a function of time; (b) Tauc plot for the evaluation of the band gap using 24 h UV-vis spectrum.
3.2. Vibrational Study
The FTIR spectrum of LHE (black line) along with LHE-assisted HAgNPs (red line) is shown in Figure 2. The obtained infrared spectra showed a wide absorption peak of around 3248 cm−1 linked to stretching of the hydroxyl (OH) functional group present in alcohols, phenols, flavonoids, etc. in the LHE. The FTIR spectrum of extract-assisted HAgNPs shows that the hydroxyl (OH) absorption peak shifted to 3228 cm−1, becoming broader and decreasing in intensity. This shift and change in intensity suggests the involvement of hydroxyl groups for the stabilization and capping of AgNPs, likely through interactions such as hydrogen bonding or coordination with Ag+ ions during the synthesis process. Similar results are reported in previous studies [28]. Besides the hydroxyl (OH) absorption peak, there are two further absorption peaks obtained around the region of 1700–1000 cm−1. The IR absorption band around 1612 cm−1 is attributed to the stretching vibrations of the (NH) C=O group of amide (I) in proteins [14]. This peak shifted to 1586 cm−1 with a decrease in intensity of prepared HAgNPs, indicating the involvement of biomolecules from the husk aqueous extract in the reducing and stabilization process, as these functional groups likely bind to the nanoparticle surface. The absorption band at 1036 cm−1 corresponds to the C–O bond stretching in amino acids [29]. In the case of HAgNPs, the peak appears at 1002 cm−1.

Figure 2.
FTIR spectrum of synthesized HAgNPs (red line) and red lentil husk aqueous extract (black line).
By comparing the FTIR bands that appeared in Figure 2, it was possible to obtain a hint about the major functional groups, namely that polyphenols, and amino acids were accountable for silver ion (Ag+) reduction to formsilver metal (Ag) and also served as agents for capping and as stabilizers for the prepared HAgNPs. The outcomes of the present investigation are analogous and consistent with various previous studies [14,26].
3.3. FESEM and EDX Examination
The surface morphology, shape, and size of the prepared HAgNPs can be observed through the FESEM study, and the observed image is shown in Figure 3a. From the figure, the prepared HAgNPs seem to be spherical and highly agglomerated. In previous study, rod-shaped and sphere-shaped silver particles of an average dimension of 15.76 nm were reported by using a fresh Tulsi leaf (Ocimum canum) aqueous extract [30]. In another study, the SEM image exhibited spherical particles using Moringa-leaf-extract-mediated AgNPs with a particle size distribution of between 10 and 25 nm [31]. It is important to mention that different morphological silver nanoparticles are formed even though a similar synthesis methodology was followed [30]. The average size of the prepared nanoparticles of this study was determined to be 73 nm based on SEM imaging and Image J analysis. This size differs from the size observed from the Debye–Scherrer equation (eq-1) and obtained XRD spectrum of this study (8.9 nm), and this difference between the sizes of the prepared nanoparticles from the XRD spectrum analysis could be due to agglomerated particles in the evaluation of size using Image J software [17].

Figure 3.
(a) An SEM image of prepared HAgNPs at a scale bar of 1.00 μm. (b) Particle size distribution histogram using Image J software and an SEM image.
Figure 4 shows the elemental analysis along with the weight percentage of different elements present in the prepared HAgNPs. As can be seen in Figure 4, there is a strong peak at about 3 keV corresponding to the silver nanocrystal, and a similar peak was visible in other studies as well [2,32]. The presence of other elements is attributed to biomolecules existing in the LHE used during the synthesis process which are expected to remain attached to the nanoparticle surface. The FTIR spectrum further confirmed the involvement of these biomolecules, as indicated by specific peaks corresponding to functional groups such as hydroxyl (-OH) and (NH) C=O which enhance the stability and functionalization of the nanoparticles [3,13].

Figure 4.
An energy dispersive X-ray spectrum of prepared HAgNPs.
3.4. Structural Analysis
An XRD analysis is helpful for understanding the phase purity as well as the crystallinity of the prepared nanomaterials. The XRD spectrum of the prepared sample showed five distinct diffraction peaks at 38.26°, 44.04°, 64.54°, 77.54° and 81.81°, corresponding to (111), (200), (101), (220), (311), and (222) crystal planes of HAgNPs, respectively (Figure 5). These peaks are closely matched with the FCC silver nanoparticles diffraction peaks according to the JCPDS data card No. 03-0921. No peaks other than crystalline silver peaks were obtained, which hinted the phase purity of the prepared HAgNPs [33]. The average dimension of the prepared HAgNPs is determined as 8.9 nm from the (111) plane using the Debye–Scherrer equation. Different sizes of the AgNPs were reported in previous studies when different plant parts aqueous extract were applied for the preparation of AgNPs. AgNPs made from the application of Eugenia roxburghii DC leaf extract had a size of 35 nm [34], whereas Nishibuchi et al. prepared 3.42 nm-sized AgNPs using tea leaf (Camellia sinensis) aqueous extract [35].

Figure 5.
An XRD pattern of silver nanoparticles formed along with the JCPDS (card no 03-0921) pattern.
3.5. Estimation of Total Phenolic and Flavonoid Content
Phenolic and flavonoids are an important group of plant secondary metabolites that exhibit significant biological activities. Lens culinaris is an important plant consumed in Asia and North America that is rich in different phenolic and flavonoid compounds, including phenolic acids, proanthocyanidins, tannins, flavonols, and anthocyanins [36]. These compounds exhibit significant antioxidant capacities and help to prevent various degenerative diseases in humans. The bioactive compounds are also involved in converting Ag+ ions into metallic Ag0 forms, which are then capped and stabilized as silver nanoparticles (AgNPs) [37]. In this study, the aqueous LHE contained 140.24 ± 0.76 mg of GAE/g for total phenolic content and 15.76 ± 0.64 mg of QE/g for total flavonoid content, based on the standard calibration curve. The standard gallic acid calibration curve and the quercetin calibration curves are shown in Figure 6a,b. Similarly to our study, methanol extracts of L. culinaris of Nepalese origin were found to contain TPC and TFC of 41.65 ± 1.32 mg GAE/g and 160.24 ± 4.07 mg QE/g, respectively [38].

Figure 6.
Calibration curves for (a) gallic acid; (b) quercetin: concentration vs. absorbance at their respective maximum absorbance wavelengths (λmax).
3.6. Antioxidant Capacity
The antioxidant capacity of the LHE and HAgNPs was performed by the DPPH technique, which is the simplest method that measures the relative reduction in absorbance of the DPPH radical by the test sample at a wavelength of 517 nm [39]. Here, we assessed the radical scavenging capacity of both the extract and the AgNPs, comparing them to ascorbic acid. Figure 7 indicates that the HAgNPs exhibit significantly higher activity compared to the extract. The higher activity of the HAgNPs is further confirmed by their lower half-maximal inhibitory concentration (IC50) of 38.87 ± 3.52 µg/mL compared to that of LHE, which was 65.27 ± 1.17 µg/mL. Ascorbic acid exhibited the highest antioxidant capacity, showing the lowest IC50 value of 10.60 ± 1.23 μg/mL. The enhanced antioxidant activity of silver nanoparticles synthesized using LHE can be ascribed to the mutual contributions of the bioactive molecules and the unique features of the HAgNPs. The bioactive compounds, including phenolics, terpenoids, and flavonoids, function as both reducing and capping agents during synthesis, stabilizing the nanoparticles and imparting additional antioxidant properties. The capping molecules provide functional groups that can donate electrons or hydrogen atoms aiding in the neutralization of reactive oxygen species (ROS) and disrupt oxidative stress pathways [40]. Moreover, the nanoscale size and enlarge surface area of HAgNPs enable better interaction with free radicals, amplifying their scavenging potential. This dual contribution from the intrinsic properties of AgNPs and the antioxidant-rich bioactive molecules from the extract results in significantly improved antioxidant efficiency. This is further supported by the fact that AgNPs exhibit higher antioxidant activity compared to their corresponding crude extract [41,42]. Similar results of enhanced antioxidant activity were presented by Khanal et al. during the fabrication of AgNPs by applying the root extract of Rubus ellipticus [13].

Figure 7.
Variation in % scavenging capacity with concentration.
3.7. Antibacterial Study
The antibacterial susceptibility of crude aqueous extract and fabricated HAgNPs was evaluated by an agar well diffusion scheme against some pathogens (S. aureus, S. sonnei, K. pneumoniae, and E. faecalis). The outcome of the antibacterial study is presented in Table 1 and the photographs (Figure 8). Antibacterial tests showed that the crude aqueous extract of the lentil husk was found to be ineffective in Gram-positive S. aureus and E. faecalis and Gram-negative S. sonnei; however, it was effective in K. pneumoniae Table 1 (Figure 8). Further, the synthesized HAgNPs exhibited notable antibacterial activity at concentrations of 1.3 mg/mL and 2.5 mg/mL. The HAgNPs resulted in zones of inhibitions of 13.0 and 14.0 mm against K. pneumoniae and 13.0 and 15.0 mm against E. faecalis at concentrations of 1.3 and 2.5 mg/mL, respectively. Similarly, ZOIs of 13.0 and 14.0 mm were observed for each of S. aureus and S. sonnei at concentrations of 1.3 mg/mL. In S. sonnei and S. aureus, the zone of inhibition values were increased by 1.0 mm, indicating no notable effect of concentration on the antibacterial efficacy of the HAgNPs. Several scientific studies have indicated that physicochemical properties like dimension, shape, surface charge, capping means, etc. greatly affect the antibacterial properties of nanoparticles [43,44]. We observed a noticeably smaller zone of inhibition (ZOI) at higher concentrations (5 mg/mL) of the prepared HAgNPs. This smaller ZOI could be due to the aggregation of HAgNPs at greater concentrations, which lessens the active surface area and potentially prevents silver ions entering to the microbial cells. Additionally, higher concentrations may also interfere with the uniform distribution of nanoparticles, leading to reduced efficacy. In another study on the preparation of silver nanoparticles (AgNPs) by Carduus crispus extract, the plant extract itself was inactive; nonetheless, the resulting silver nanoparticles displayed a noteworthy antibacterial activity that is analogous to our results [24].

Table 1.
Results of an antibacterial test of crude extract and HAgNPs.
Figure 8.
Antibacterial activity of synthesized HAgNPs (A = LHE, 1.3 = 1.3 mg/mL and 2.5 = 2.5 mg/mL 5 = 5 mg/mL of synthesized HAgNPs, respectively, in 50% DMSO, NC = negative control = distilled water).
A concrete antibacterial mechanism for AgNPs has yet to be scientifically established; however, the literature suggests that AgNPs penetrate the bacterial cells, releasing silver (Ag+) ions that inactivate several respiratory enzymes and inhibit their actions, leading to the self-destruction of cells [45]. In the agar well diffusion technique, an inhibition zone forms due to the destabilization of the bacterial cell wall and destruction of the plasma membrane. When the concentration increased, larger numbers of bacteria were killed and a bigger zone of inhibition was detected [46].
4. Conclusions
In the present investigation, green production of silver nanoparticles (HAgNPs) is proposed by the application of an aqueous extract of waste red lentil husk. The created nanoparticles exhibited a characteristic optical response at 420 nm in the UV-vis spectroscopy analysis, suggesting the formation of HAgNPs. The XRD analysis of prepared samples revealed that the prepared NPS are crystalline and that their size was found to be 8.9 nm by the Debye–Scherer equation. An FTIR analysis of the prepared sample inferred that different functional groups, such as polyphenols, and amino acids, present in biomolecules of LHE are accountable for silver ion (Ag+) reduction in the forming of silver metal (Ag°) while also serving as agents for capping and stabilization. The antibacterial property of prepared HAgNPs was examined towards both Gram-positive and Gram-negative bacterial strains, revealing that the prepared HAgNPs are effective in regard to showing antibacterial properties. The synthesized HAgNPs showed greater antioxidant activity compared to the crude extract. However, the potential leaching of silver ions during these applications was not investigated. Silver ion release may affect both the nanoparticles’ long-term efficacy and their environmental impact. To address this limitation, future studies should include leaching tests to assess the stability and safety of prepared HAgNPs in real-world applications.
Author Contributions
K.P. and L.N.K.: Conceptualization, methodology, investigation, validation, formal analysis, writing—original draft. G.G., S.K. and S.B.: conceptualization, writing—review and editing. D.K. and M.L.S.: methodology, data curation, visualization, review and editing. B.P. and B.R.P.: methodology, data curation, conceptualization, formal analysis. All authors have read and agreed to the published version of the manuscript.
Funding
This research received no external funding.
Data Availability Statement
Data are contained within the article.
Conflicts of Interest
The authors declare that they have no known competing financial interests or personal relationships that could have appeared to influence the work reported in this paper.
References
- Shuaib, U.; Hussain, T.; Ahmad, R.; Zakaullah, M.; Mubarik, F.E.; Muntaha, S.T.; Ashraf, S. Plasma-liquid synthesis of silver nanoparticles and their antibacterial and antifungal applications. Mater. Res. Express 2020, 7, 035015. [Google Scholar] [CrossRef]
- Menon, S.; Agarwal, H.; Kumar, S.R.; Kumar, S.V. Green synthesis of silver nanoparticles using medicinal plant Acalypha indica leaf extracts and its application as an antioxidant and antimicrobial agent against foodborne pathogens. Int. J. Appl. Pharm. 2017, 9, 42. [Google Scholar] [CrossRef]
- Matar, G.H.; Akyüz, G.; Kaymazlar, E.; Andac, M. An investigation of green synthesis of silver nanoparticles using Turkish honey against pathogenic bacterial strains. Biointerface Res. Appl. Chem. 2023, 13, 195. [Google Scholar] [CrossRef]
- Vanlalveni, C.; Lallianrawna, S.; Biswas, A.; Selvaraj, M.; Changmai, B.; Rokhum, S.L. Green synthesis of silver nanoparticles using plant extracts and their antimicrobial activities: A review of recent literature. RSC Adv. 2021, 11, 2804–2837. [Google Scholar] [CrossRef] [PubMed]
- Singh, A.; Gautam, P.K.; Verma, A.; Singh, V.; Shivapriya, P.M.; Shivalkar, S.; Sahoo, A.K.; Samanta, S.K. Green synthesis of metallic nanoparticles as effective alternatives to treat antibiotics resistant bacterial infections: A Review. Biotechnol. Rep. 2020, 25, e00427. [Google Scholar] [CrossRef]
- Khadka, D.; Gautam, P.; Dahal, R.; Ashie, M.D.; Paudyal, H.; Ghimire, K.N.; Pant, B.; Poudel, B.R.; Bastakoti, B.P.; Pokhrel, M.R. Evaluating the photocatalytic activity of green synthesized iron oxide nanoparticles. Catalysts 2024, 14, 751. [Google Scholar] [CrossRef]
- Vinay, S.P.; Udayabhanu; Nagarju, G.; Chandrappa, C.P.; Chandrasekhar, N. Enhanced photocatalysis, photoluminescence, and anti-bacterial activities of nanosize ag: Green synthesized via Rauvolfia tetraphylla (Devil Pepper). SN Appl. Sci. 2019, 1, 477. [Google Scholar] [CrossRef]
- Joudeh, N.; Linke, D. Nanoparticle classification, physicochemical properties, characterization, and applications: A comprehensive review for biologists. J. Nanobiotechnol. 2022, 20, 262. [Google Scholar] [CrossRef]
- Rafique, M.; Sadaf, I.; Rafique, M.S.; Tahir, M.B. A review on green synthesis of silver nanoparticles and their applications. Artif. Cells Nanomed. Biotechnol. 2017, 45, 1272–1291. [Google Scholar] [CrossRef]
- Golabiazar, R.; Othman, K.I.; Khalid, K.M.; Maruf, D.H.; Aulla, S.M.; Yusif, P.A. Green synthesis, characterization, and investigation antibacterial activity of silver nanoparticles using Pistacia atlantica leaf extract. Bionanoscience 2019, 9, 323–333. [Google Scholar] [CrossRef]
- Tang, K.W.K.; Millar, B.C.; Moore, J.E. Antimicrobial resistance (AMR). Br. J. Biomed. Sci. 2023, 80, 11387. [Google Scholar] [CrossRef] [PubMed]
- Murray, C.J.L.; Ikuta, K.S.; Sharara, F.; Swetschinski, L.; Robles Aguilar, G.; Gray, A.; Han, C.; Bisignano, C.; Rao, P.; Wool, E.; et al. Global burden of bacterial antimicrobial resistance in 2019: A systematic analysis. Lancet 2022, 399, 629–655. [Google Scholar] [CrossRef] [PubMed]
- Khanal, L.N.; Sharma, K.R.; Paudyal, H.; Parajuli, K.; Dahal, B.; Ganga, G.C.; Pokharel, Y.R.; Kalauni, S.K. Green synthesis of silver nanoparticles from root extracts of Rubus ellipticus and comparison of antioxidant and antibacterial activity. J. Nanomater. 2022, 2022, 1832587. [Google Scholar] [CrossRef]
- Sharifi-Rad, M.; Elshafie, H.S.; Pohl, P. Green Synthesis of silver nanoparticles (AgNPs) by Lallemantia royleana leaf extract: Their bio-pharmaceutical and catalytic properties. J. Photochem. Photobiol. A Chem. 2024, 448, 115318. [Google Scholar] [CrossRef]
- Chandrasekharan, S.; Chinnasamy, G.; Bhatnagar, S. Sustainable phyto-fabrication of silver nanoparticles using Gmelina arborea exhibit antimicrobial and biofilm inhibition activity. Sci. Rep. 2022, 12, 156. [Google Scholar] [CrossRef]
- Singh, C.; Kumar, J.; Kumar, P.; Chauhan, B.S.; Tiwari, K.N.; Mishra, S.K.; Srikrishna, S.; Saini, R.; Nath, G.; Singh, J. Green synthesis of silver nanoparticles using aqueous leaf extract of Premna integrifolia (l.) rich in polyphenols and evaluation of their antioxidant, antibacterial and cytotoxic activity. Biotechnol. Biotechnol. Equip. 2019, 33, 359–371. [Google Scholar] [CrossRef]
- Parajuli, K.; Malla, K.P.; Panchen, N.; Ganga, G.C.; Adhikari, R. Isolation of antibacterial nano-hydroxyapatite biomaterial from waste buffalo bone and its characterization. Chem. Chem. Technol. 2022, 16, 133–141. [Google Scholar] [CrossRef]
- Ainsworth, E.A.; Gillespie, K.M. Estimation of total phenolic content and other oxidation substrates in plant tissues using folin–ciocalteu reagent. Nat. Protoc. 2007, 2, 875–877. [Google Scholar] [CrossRef]
- Nelly Makhubu, F.; Omotayo Tom Ashafa, A.; Fouché, G.; Oladunni Balogun, F. Phytochemical screening, free radical mitigation and antidiabetic potentials of Pentanisia prunelloides (Klotzsch Ex Eckl. & Zeyh.) Walp. Root Extracts. J. Food Nutr. Res. 2019, 7, 391–401. [Google Scholar] [CrossRef]
- Pawar, S.S.; Dasgupta, D. Quantification of phenolic content from stem-bark and root of Hugonia mystax linn. using RP-HPLC. J. King Saud Univ.-Sci. 2018, 30, 293–300. [Google Scholar] [CrossRef]
- Lyu, J.I.; Ryu, J.; Seo, K.-S.; Kang, K.-Y.; Park, S.H.; Ha, T.H.; Ahn, J.-W.; Kang, S.-Y. Comparative study on phenolic compounds and antioxidant activities of hop (Humulus lupulus L.) strobile extracts. Plants 2022, 11, 135. [Google Scholar] [CrossRef] [PubMed]
- Phull, A.-R.; Abbas, Q.; Ali, A.; Raza, H.; Kim, S.J.; Zia, M.; Haq, I. Antioxidant, cytotoxic and antimicrobial activities of green synthesized silver nanoparticles from crude extract of Bergenia ciliata. Futur. J. Pharm. Sci. 2016, 2, 31–36. [Google Scholar] [CrossRef]
- Murray, P.R.; Baron, E.J.; Jorgensen, J.H.; Landry, M.L. Manual of Clinical Microbiology, 9th ed.; Murray, P.R., Baron, E.J., Jorgensen, J.H., Landry, M.L., Eds.; American Society for Microbiology: Washington, DC, USA, 2007. [Google Scholar]
- Urnukhsaikhan, E.; Bold, B.-E.; Gunbileg, A.; Sukhbaatar, N.; Mishig-Ochir, T. Antibacterial activity and characteristics of silver nanoparticles biosynthesized from Carduus crispus. Sci. Rep. 2021, 11, 21047. [Google Scholar] [CrossRef] [PubMed]
- Zhang, X.F.; Liu, Z.G.; Shen, W.; Gurunathan, S. Silver nanoparticles: Synthesis, characterization, properties, applications, and therapeutic approaches. Int. J. Mol. Sci. 2016, 17, 1534. [Google Scholar] [CrossRef]
- Aziz, A.; Khalid, M.; Akhtar, M.S.; Nadeem, M.; Gilani, Z.A.; Ul Huda Khan Asghar, H.M.N.; Rehman, J.; Ullah, Z.; Saleem, M. Structural, morphological and optical investigations of silver nanoparticles synthesized by sol-gel auto-combustion method. Dig. J. Nanomater. Biostruct. 2018, 13, 679–683. [Google Scholar]
- Calderón-Jiménez, B.; Montoro Bustos, A.R.; Pereira Reyes, R.; Paniagua, S.A.; Vega-Baudrit, J.R. Novel pathway for the sonochemical synthesis of silver nanoparticles with near-spherical shape and high stability in aqueous media. Sci. Rep. 2022, 12, 882. [Google Scholar] [CrossRef]
- Aziz, N.; Faraz, M.; Sherwani, M.A.; Fatma, T.; Prasad, R. Illuminating the anticancerous efficacy of a new fungal chassis for silver nanoparticle synthesis. Front. Chem. 2019, 7, 65. [Google Scholar] [CrossRef]
- Barth, A. The infrared absorption of amino acid side chains. Prog. Biophys. Mol. Biol. 2000, 74, 141–173. [Google Scholar] [CrossRef]
- Tailor, G.; Yadav, B.L.; Chaudhary, J.; Joshi, M.; Suvalka, C. Green synthesis of silver nanoparticles using Ocimum canum and their anti-bacterial activity. Biochem. Biophys. Rep. 2020, 24, 100848. [Google Scholar] [CrossRef]
- Asif, M.; Yasmin, R.; Asif, R.; Ambreen, A.; Mustafa, M.; Umbreen, S. Green synthesis of silver nanoparticles (AgNPs), structural characterization, and their antibacterial potential. Dose-Response 2022, 20, 1–11. [Google Scholar] [CrossRef]
- Basalius, H.; Mani, A.; Michael, A.; Mary, S.M.; Lenin, M.; Chelliah, P.; Siddiqui, M.R.; Wabaidur, S.M.; Islam, M.A. Green synthesis of nano-silver using Syzygium samarangense flower extract for multifaceted applications in biomedical and photocatalytic degradation of methylene blue. Appl. Nanosci. 2023, 13, 3735–3747. [Google Scholar] [CrossRef]
- Dua, T.K.; Giri, S.; Nandi, G.; Sahu, R.; Shaw, T.K.; Paul, P. Green synthesis of silver nanoparticles using eupatorium adenophorum leaf extract: Characterizations, antioxidant, antibacterial and photocatalytic activities. Chem. Pap. 2023, 77, 2947–2956. [Google Scholar] [CrossRef]
- Giri, A.K.; Jena, B.; Biswal, B.; Pradhan, A.K.; Arakha, M.; Acharya, S.; Acharya, L. Green synthesis and characterization of silver nanoparticles using Eugenia roxburghii DC. extract and activity against biofilm-producing bacteria. Sci. Rep. 2022, 12, 8383. [Google Scholar] [CrossRef] [PubMed]
- Loo, Y.Y.; Chieng, B.W.; Nishibuchi, M.; Radu, S. Synthesis of silver nanoparticles by using tea leaf extract from Camellia sinensis. Int. J. Nanomed. 2012, 7, 4263–4267. [Google Scholar] [CrossRef]
- Mustafa, A.M.; Abouelenein, D.; Acquaticci, L.; Alessandroni, L.; Angeloni, S.; Borsetta, G.; Caprioli, G.; Nzekoue, F.K.; Sagratini, G.; Vittori, S. Polyphenols, saponins and phytosterols in lentils and their health benefits: An overview. Pharmaceuticals 2022, 15, 1225. [Google Scholar] [CrossRef]
- Alex, A.M.; Subburaman, S.; Chauhan, S.; Ahuja, V.; Abdi, G.; Tarighat, M.A. Green synthesis of silver nanoparticle prepared with ocimum species and assessment of anticancer potential. Sci. Rep. 2024, 14, 11707. [Google Scholar] [CrossRef]
- Sharma, K.R.; Giri, G. Quantification of phenolic and flavonoid content, antioxidant activity, and proximate composition of some legume seeds grown in Nepal. Int. J. Food Sci. 2022, 2022, 4629290. [Google Scholar] [CrossRef]
- Qubtia, M.; Ghumman, S.A.; Noreen, S.; Hameed, H.; Noureen, S.; Kausar, R.; Irfan, A.; Akhtar Shah, P.; Afzal, H.; Hameed, M.; et al. Evaluation of plant-based silver nanoparticles for antioxidant activity and promising wound-healing applications. ACS Omega 2024, 9, 12146–12157. [Google Scholar] [CrossRef]
- Mikhailova, E.O. Silver nanoparticles: Mechanism of action and probable bio-application. J. Funct. Biomater. 2020, 11, 84. [Google Scholar] [CrossRef]
- Shrestha, D.K.; Magar, A.B.; Bhusal, M.; Baraili, R.; Pathak, I.; Joshi, P.R.; Parajuli, N.; Sharma, K.R. Synthesis of silver and zinc oxide nanoparticles using polystichum lentum extract for the potential antibacterial, antioxidant, and anticancer activities. J. Chem. 2024, 2024, 1876560. [Google Scholar] [CrossRef]
- Bedlovičová, Z.; Strapáč, I.; Baláž, M.; Salayová, A. A brief overview on antioxidant activity determination of silver nanoparticles. Molecules 2020, 25, 3191. [Google Scholar] [CrossRef] [PubMed]
- Bruna, T.; Maldonado-Bravo, F.; Jara, P.; Caro, N. Silver nanoparticles and their antibacterial applications. Int. J. Mol. Sci. 2021, 22, 7202. [Google Scholar] [CrossRef] [PubMed]
- Sondi, I.; Salopek-Sondi, B. Silver Nanoparticles as antimicrobial agent: A case study on E. coli as a model for Gram-negative bacteria. J. Colloid Interface Sci. 2004, 275, 177–182. [Google Scholar] [CrossRef] [PubMed]
- Nisar, P.; Ali, N.; Rahman, L.; Ali, M.; Shinwari, Z.K. Antimicrobial activities of biologically synthesized metal nanoparticles: An insight into the mechanism of action. J. Biol. Inorg. Chem. 2019, 24, 929–941. [Google Scholar] [CrossRef]
- Khan, A.N.; Ali Aldowairy, N.N.; Saad Alorfi, H.S.; Aslam, M.; Bawazir, W.A.B.; Hameed, A.; Soomro, M.T. Excellent antimicrobial, antioxidant, and catalytic activities of medicinal plant aqueous leaf extract derived silver nanoparticles. Processes 2022, 10, 1949. [Google Scholar] [CrossRef]
Disclaimer/Publisher’s Note: The statements, opinions and data contained in all publications are solely those of the individual author(s) and contributor(s) and not of MDPI and/or the editor(s). MDPI and/or the editor(s) disclaim responsibility for any injury to people or property resulting from any ideas, methods, instructions or products referred to in the content. |
© 2025 by the authors. Licensee MDPI, Basel, Switzerland. This article is an open access article distributed under the terms and conditions of the Creative Commons Attribution (CC BY) license (https://creativecommons.org/licenses/by/4.0/).